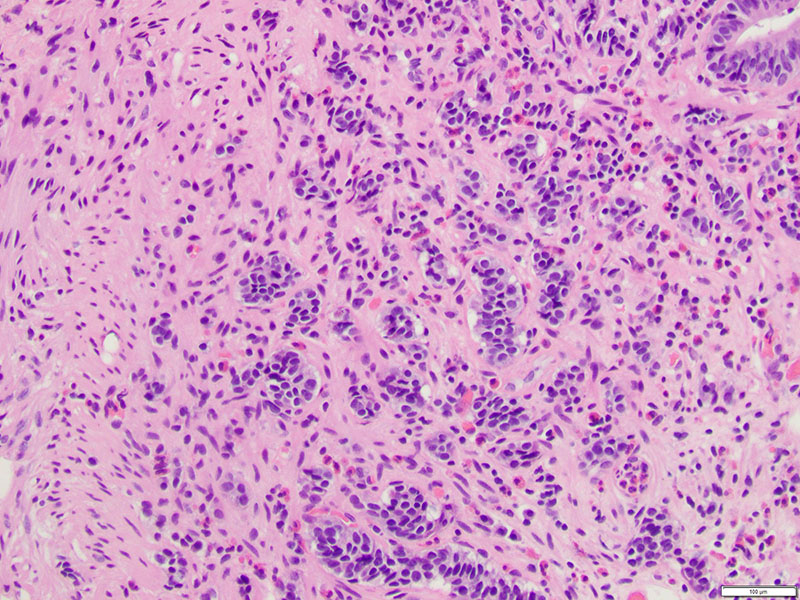

Case of the Month: Fatigue and Constipation
By Joseph Blitman, M.B.B.Ch., B.A.O, Aaron R. Huber, D.O., Phoenix D. Bell, M.D., M.S.
Clinical History
A 75-year-old male with a past medical history of coronary artery disease, hypertension, and chronic obstructive pulmonary disease, presents with fatigue and constipation. A complete blood count reveals a hemoglobin level of 9.8 g/dL (normal: 14-18 g/dL) and a hematocrit level of 32.6% (normal: 39-52%).
Recent History
The patient is sent for an esophagogastroduodenoscopy (EGD), which reveals a 2 c.m. polyp in the third segment of the duodenum. Biopsy confirms duodenal adenoma, for which the patient elects to undergo an EGD with endoscopic mucosal resection (EMR).Microscopic examination demonstrates duodenal mucosa with low-grade epithelial dysplasia overlying foci of bland, monotonous cells with scant cytoplasm (Figures 1 & 2). The cells are arranged in nests and trabeculae that infiltrate into the superficial muscularis mucosae (Figure 3). Immunohistochemistry shows positive staining for synaptophysin (Figure 4) and chromogranin (Figure 5), as well as a Ki-67 labeling index < 1% (Figure 6).